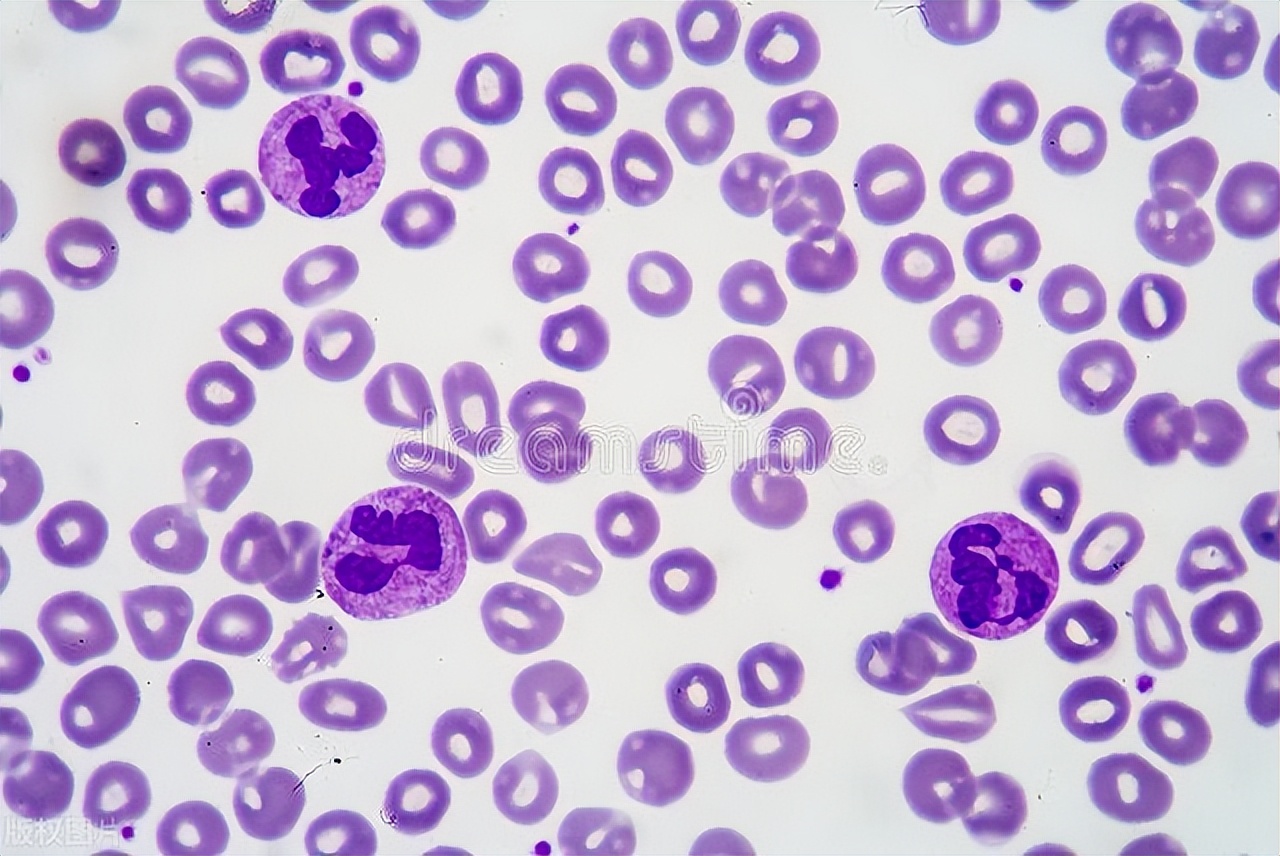
血小板减少会有哪些症状呢,免疫性血小板减少症症状

血小板减少是指外周血中血小板的数量低于正常范围,血液中血小板计数<100×10^9/L。血小板减少程度较轻者,会有鼻出血,牙龈出血,口腔黏膜出血的症状;重者可表现为脏器出血,特别是致命的颅内出血。血小板减少常见于多种血液性疾病、风湿免疫病、放化疗损伤及药物相关性血小板减少。

按照血小板减少的程度可分轻、中、重度。血小板的正常值是(125~350)×10^9/L,一般在(70~80)×10^9/L为轻度减低,低于50×10^9/L为中度减低,小于20×10^9/L为重度减低。
再生障碍性贫血和骨髓病性疾病,最早出现的表现就是血小板减少;氯噻嗪类药及其协同剂,这些选择性抑制巨核细胞的因素,也可引起血小板减少。
诱发血小板减少的原因较多,可能源于血小板产生不足,脾脏对血小板的阻留,血小板破坏或利用增加,血小板分泌异常以及丢失等。不管何种原因,血小板减少较严重的情况,都会引起典型的出血。
血小板减少会引起鼻、牙龈、口腔黏膜、胃肠道出血等系列症状,还可出现月经血量增多、血尿等,皮肤上会出现大小不等的出血点或者淤斑,严重的情况还会引起内脏出血,特别是致命的颅内出血。

血小板减少,临床上一般选择合适的激素类药物治疗,维持血小板数量的正常,避免身体的出血,同时还会输注血小板,应用止血剂,应用血小板生成素和支持治疗。